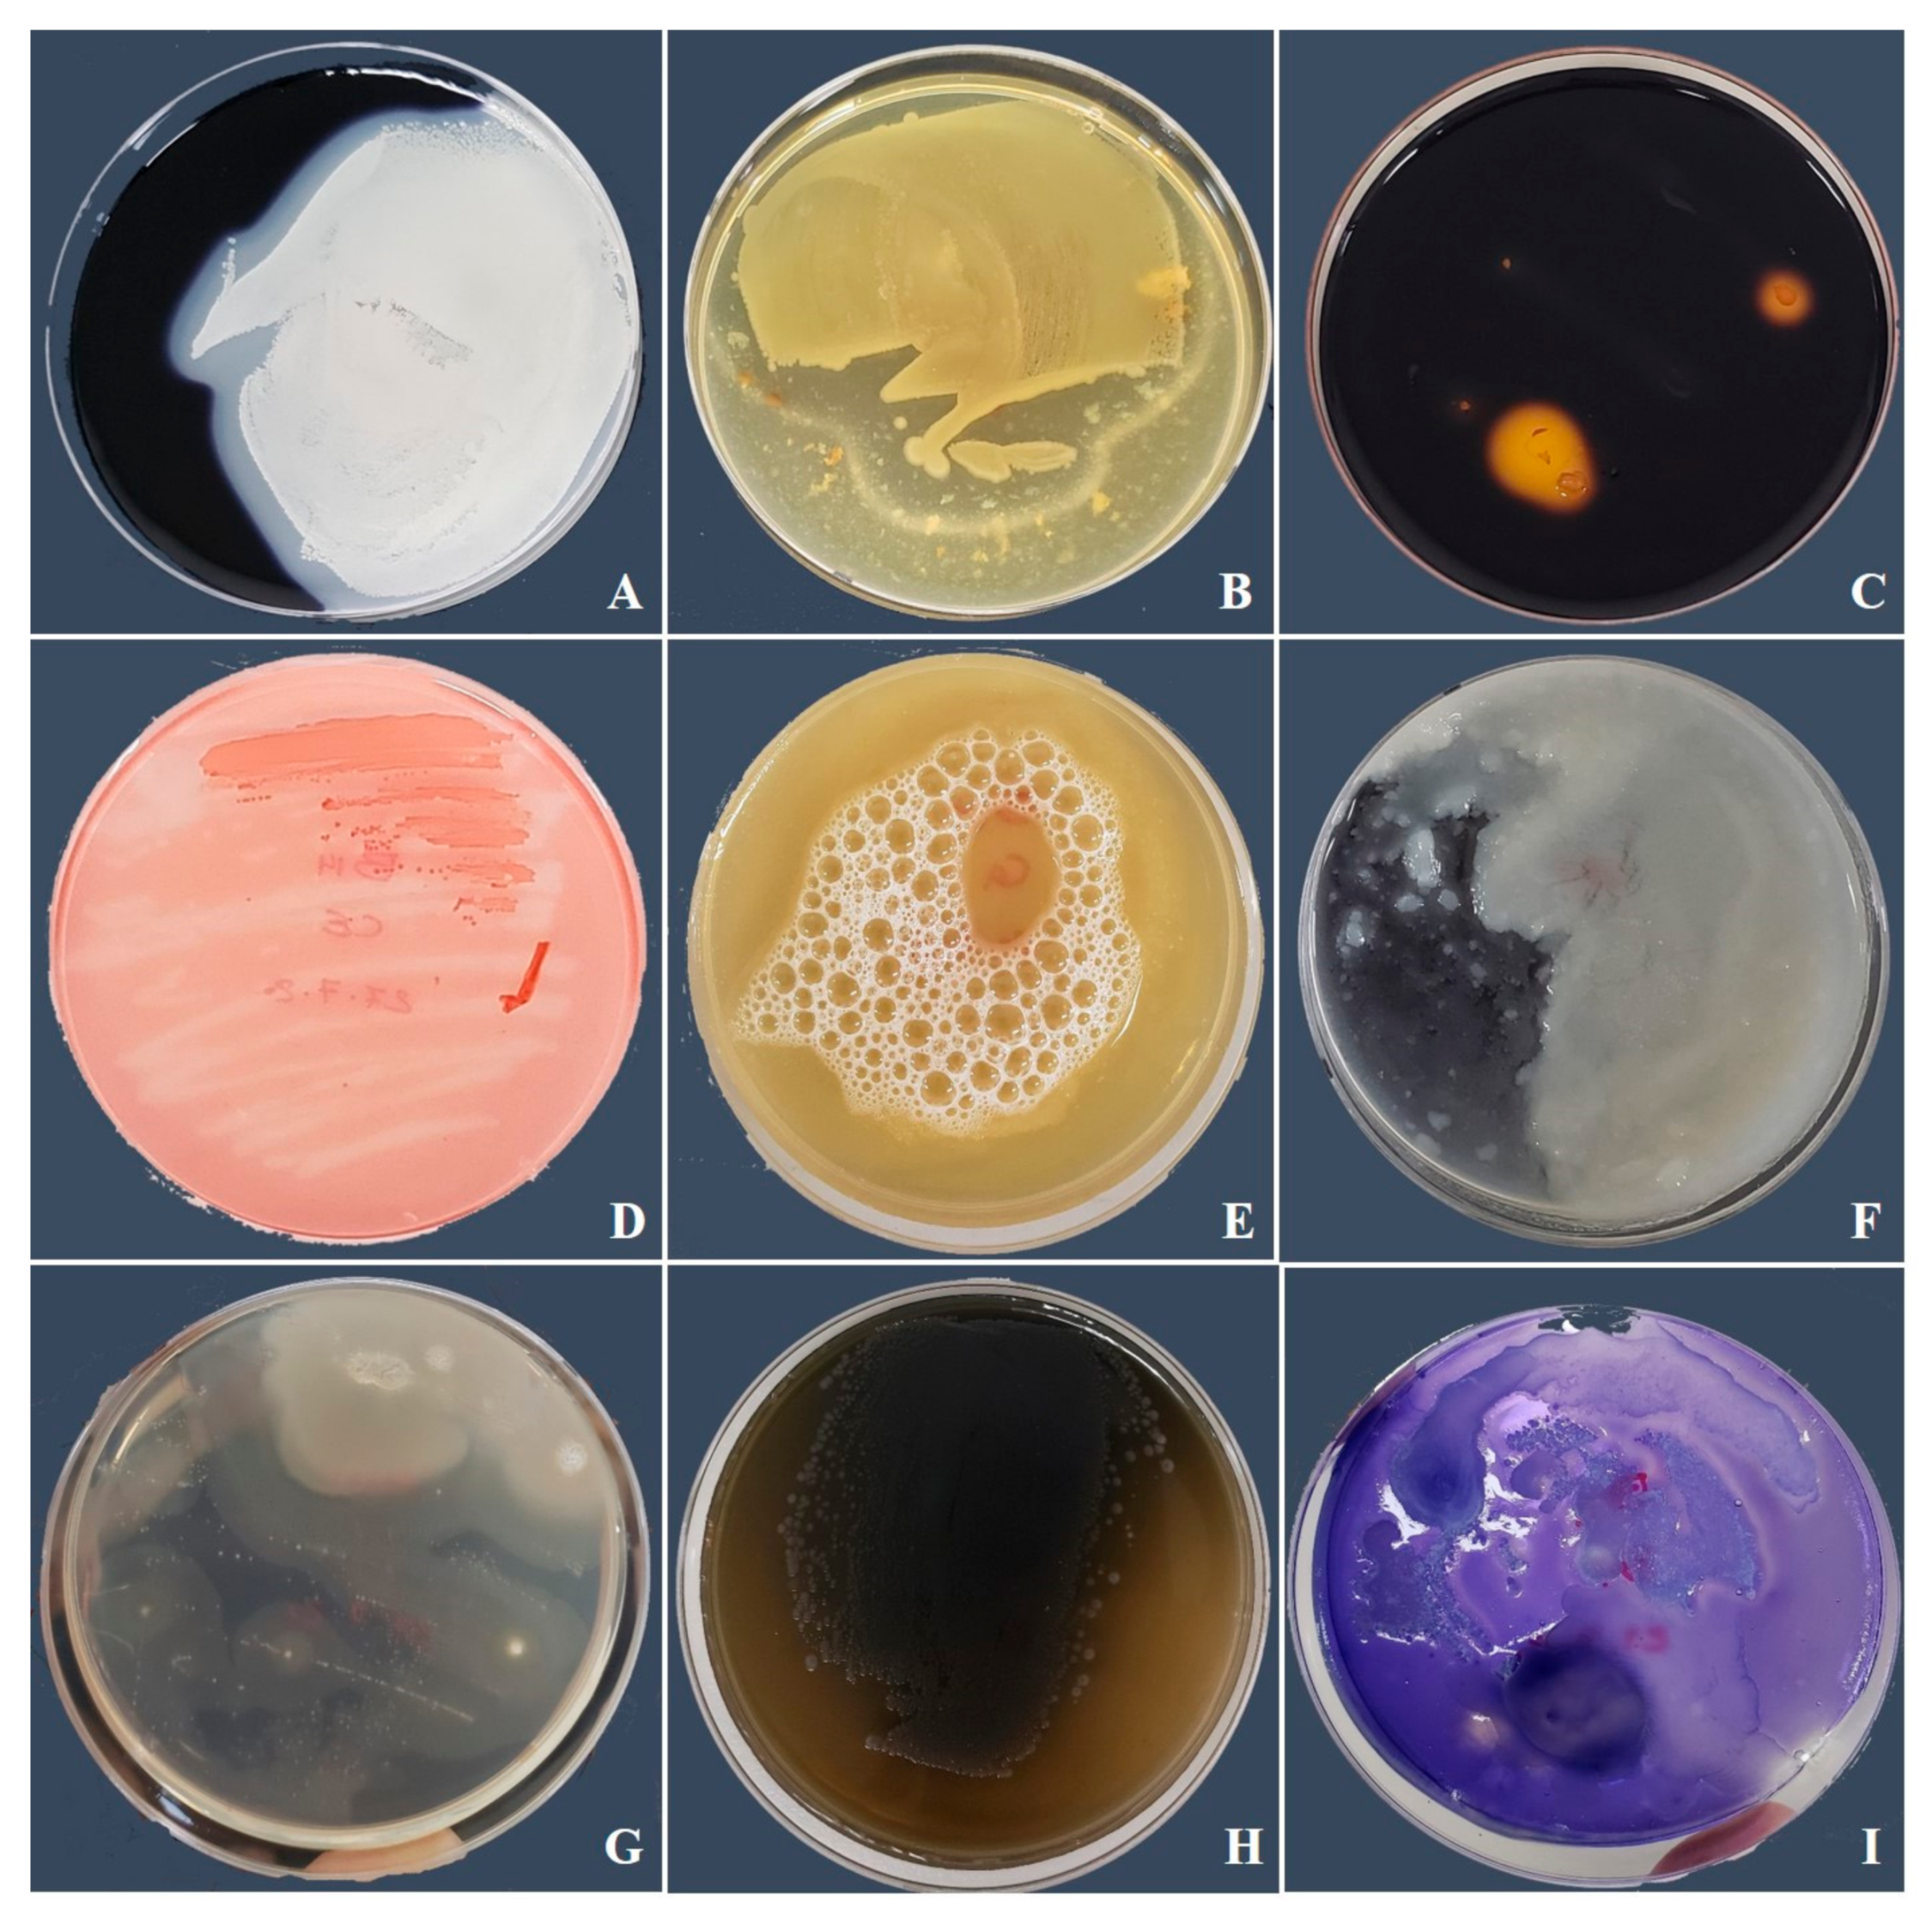

Biocontrol Potential of Bacillus amyloliquefaciens against Botrytis pelargonii and Alternaria alternata on Capsicum annuum
Abstract
1. Introduction
2. Materials and Methods
2.1. Collection Site and Isolation of Fungal Pathogens
2.2. Molecular Characterization of Fungal Isolates
2.3. Pathogenicity of Fungal Isolates in Pepper Seedlings
2.4. In Vitro Evaluation of the Antifungal Activity of the Bacterial Strain Against Fungal Pathogens
2.5. Determination of Hydrolytic Enzyme Activity of the Bacterial Strain
2.6. In Vivo Evaluation of the Antifungal Activity of the PGPR against ALT and BOT
Preparation of the Fungal and Bacterial Inocula
2.7. Plant Material and Growing Conditions
2.8. Experimental Design
2.9. Determination of Soil Moisture, pH, and Electrical Conductivity (EC)
2.10. Physio-Biochemical Attributes of the Pepper Plant
Plant Growth Characteristics and Photosynthetic Pigments
2.11. Phytohormone Analysis; Abscisic acid (ABA) and Salicylic Acid (SA)
2.12. Amino Acid Content of the Leaves
2.13. Estimation of the Leaf Protein and Sugar Content
2.14. Enzymatic and Nonenzymatic Antioxidant Activity
2.15. Hydrogen Peroxide and Lipid Peroxidation (Malondialdehyde (MDA)) Contents
Quantification of the Nutrient Content in Pepper Plants
2.16. cDNA Synthesis and Real-Time PCR Analysis
2.17. Data Analysis
3. Results
3.1. Identification of Fungal Isolates
3.2. Bacillus amyloliquefaciens Antifungal Hydrolytic Enzyme Activity and Effect on the Morphology of B. pelargonii and A. alternata
3.3. Pepper Seedling Response to B. amyloliquefaciens Inoculant under Biotic Stress
Soil Properties
3.4. Impact of PGPR on Plant Growth Attributes
3.5. Chlorophyll and Carotenoid Contents
3.6. Phytohormones; ABA and SA Accumulation
3.7. Free Amino Acid Content
3.8. Soluble Protein and Sugar Contents
3.9. H2O2 and MDA Content
3.10. Antioxidant Content
3.11. Nutrient Content in Plants
3.12. Effect of B. amyloliquefaciens Treatment on the Regulation of Biotic Stress Responsive Genes
3.13. Antimicrobial and Defense-Related Protein (CaAMP1, CaPR1, and CaDEF1)
3.14. Transcription Factor WRKY2
3.15. Xyloglucan Endotransglucosylase/Hydrolase (XTH)
3.16. Binding Protein (BiP)
3.17. BCL2-Associated x Protein (BAX) Inhibitor 1 (BI-1)
3.18. RING-Type E3 Ligases (ASRF1)
3.19. Squamosa Promoter Binding Protein (SBP)
4. Discussion
5. Conclusions
Supplementary Materials
Author Contributions
Funding
Institutional Review Board Statement
Informed Consent Statement
Data Availability Statement
Acknowledgments
Conflicts of Interest
References
- Padmanabhan, P.; Cheema, A.; Paliyath, G. Solanaceous fruits including tomato, eggplant, and peppers. In Encyclopedia of Food and Health; Caballero, B., Finglas, P.M., Toldrá, F., Eds.; Academic Press: Oxford, UK, 2016; pp. 24–32. [Google Scholar]
- Food and Agriculture Organization of the United Nations (FAO). Transforming Our World: The 2030 Agenda for Sustainable Development. Available online: http://www.fao.org/ (accessed on 20 January 2021).
- Parisi, M.; Alioto, D.; Tripodi, P. Overview of Biotic Stresses in Pepper (Capsicum spp.): Sources of Genetic Resistance, Molecular Breeding and Genomics. Int. J. Mol. Sci. 2020, 21, 2587. [Google Scholar] [CrossRef] [PubMed]
- Bemmann, W.K.; Verhoeff, N.; Malathrakis, E.; Williamson, B. (Eds.) Recent Advances in Botrytis Research. In Proceedings of the 10th International Botrytis Symposium, Heraklion, Crete, Greece, 5–10 April 1992; Pudoc Scientific Publishers: Wageningen, The Netherlands, 1992. ISBN 90-220-1070-8. [Google Scholar]
- Elad, Y.; Williamson, B.; Tudzynski, P.; Delen, N. Botrytis spp. and diseases they cause in agricultural systems–An intro-duction. In Botrytis: Biology, Pathology and Control; Elad, Y., Williamson, B., Tudzynski, P., Delen, N., Eds.; Springer: Dordrecht, The Netherlands, 2007; pp. 1–8. [Google Scholar]
- Williamson, B.; Tudzynski, B.; Tudzynski, P.; Van Kan, J.A.L. Botrytis cinerea: The cause of grey mould disease. Mol. Plant Pathol. 2007, 8, 561–580. [Google Scholar] [CrossRef] [PubMed]
- Elad, Y.; Pertot, I.; Cotes Prado, A.M.; Stewart, A. Plant hosts of Botrytis spp. In Botrytis—The Fungus, the Pathogen and its Management in Agricultural Systems; Fillinger, S., Elad, Y., Eds.; Springer International Publishing: Cham, Switzerland, 2016; pp. 413–486. [Google Scholar]
- Thomma, B.P.H.J. Alternaria spp.: From general saprophyte to specific parasite. Mol. Plant Pathol. 2003, 4, 225–236. [Google Scholar] [CrossRef]
- Nasehi, A.; Bin Kadir, J.; Ashtiani, F.A.; Nasr-Esfahani, M.-H.; Wong, M.Y.; Rambe, S.K.; Ghadirian, H.; Mahmodi, F.; Golkhandan, E. Alternaria capsicicola sp. nov., a new species causing leaf spot of pepper (Capsicum annuum) in Malaysia. Mycol. Prog. 2014, 13, 1041–1048. [Google Scholar] [CrossRef]
- Sid, A.; Ezziyyani, M.; Egea-Gilabert, C.; Candela, M. Selecting Bacterial Strains for Use in the Biocontrol of Diseases Caused by Phytophthora capsici and Alternaria alternata in Sweet Pepper Plants. Biol. Plant. 2003, 46, 569–574. [Google Scholar] [CrossRef]
- Huang, C.; Sung, I. First report of Botrytis cinerea causing postharvest fruit decay of goat-horn sweet pepper in Taiwan. J. Plant Pathol. 2017, 99, 537. [Google Scholar]
- Le, T.D.; McDonald, G.; Scott, E.S.; Able, A.J. Infection pathway of Botrytis cinerea in capsicum fruit (Capsicum annuum L.). Australas. Plant Pathol. 2013, 42, 449–459. [Google Scholar] [CrossRef]
- Luo, M.; Purdy, H.; Avis, T.J. Compost bacteria provide antifungal activity against grey mold and Alternaria rot on bell pepper fruit. Botany 2019, 97, 221–230. [Google Scholar] [CrossRef]
- Naz, F.; Tariq, A.; Rauf, C.A.; Abbas, M.F.; Walsh, E.; Luo, J.; Kingsley, K.; Zhang, N.; Bennett, J.W. First Report of Botrytis cinerea Causing Gray Mold Disease of Bell Pepper (Capsicum annuum) Fruit in Pakistan. Plant Dis. 2018, 102, 1449. [Google Scholar] [CrossRef]
- Polat, I.; Baysal, Ö.; Mercati, F.; Gümrükcü, E.; Sülü, G.; Kitapcı, A.; Araniti, F.; Carimi, F. Characterization of Botrytis cinerea isolates collected on pepper in Southern Turkey by using molecular markers, fungicide resistance genes and virulence assay. Infect. Genet. Evol. 2018, 60, 151–159. [Google Scholar] [CrossRef]
- Lu, B.H.; Wang, X.H.; Wang, R.; Yang, L.N.; Liu, L.P.; Yang, C.; Gao, J.; Liu, X.N. First Report of Botrytis pelargonii Causing Postharvest Gray Mold on Fresh Ginseng Roots in China. Plant Dis. 2019, 103, 149. [Google Scholar] [CrossRef]
- Leroux, P. Chemical control of Botrytis cinerea and its resistance to chemical fungicides. In Botrytis: Biology, Pathology and Control; Elad, Y., Williamson, B., Tudzynski, P., Delen, N., Eds.; Springer: Dordrecht, The Netherlands, 2004. [Google Scholar]
- Rosslenbroich, H.-J.; Stuebler, D. Botrytis cinerea–History of chemical control and novel fungicides for its management. Crop. Prot. 2000, 19, 557–561. [Google Scholar] [CrossRef]
- Oves, M.; Khan, M.S.; Qari, H.A. Ensifer adhaerens for heavy metal bioaccumulation, biosorption, and phosphate solubilization under metal stress condition. J. Taiwan Inst. Chem. Eng. 2017, 80, 540–552. [Google Scholar] [CrossRef]
- Gerhardson, B. Biological substitutes for pesticides. Trends Biotechnol. 2002, 20, 338–343. [Google Scholar] [CrossRef]
- El-Sayed, W.S.; Akhkha, A.; El-Naggar, M.Y.; ElBadry, M. In Vitro antagonistic activity, plant growth promoting traits and phylogenetic affiliation of rhizobacteria associated with wild plants grown in arid soil. Front. Microbiol. 2014, 5, 651. [Google Scholar] [CrossRef] [PubMed]
- Messiha, N.A.S.; van Diepeningen, A.D.; Farag, N.S.; Abdallah, S.A.; Janse, J.D.; van Bruggen, A.H.C. Stenotrophomonas maltophilia: A new potential biocontrol agent of Ralstonia solanacearum, causal agent of potato brown rot. Eur. J. Plant Pathol. 2007, 118, 211–225. [Google Scholar] [CrossRef]
- Chen, X.; Koumoutsi, A.; Scholz, R.; Schneider, K.; Vater, J.; Süssmuth, R.; Piel, J.; Borriss, R. Genome analysis of Bacillus am-yloliquefaciens FZB42 reveals its potential for biocontrol of plant pathogens. J. Biotechnol. 2009, 140, 27–37. [Google Scholar] [CrossRef]
- Idriss, E.E.; Makarewicz, O.; Farouk, A.; Rosner, K.; Greiner, R.; Bochow, H.; Richter, T.; Borriss, R. Extracellular phytase activity of Bacillus amyloliquefaciens FZB45 contributes to its plant-growth-promoting effectaaThe GenBank accession numbers for the sequences determined in this work are AY055219 to AY055226. Microbiology 2002, 148, 2097–2109. [Google Scholar] [CrossRef] [PubMed]
- Beneduzi, A.; Ambrosini, A.; Passaglia, L.M. Plant growth-promoting rhizobacteria (PGPR): Their potential as antagonists and biocontrol agents. Genet. Mol. Biol. 2012, 35, 1044–1051. [Google Scholar] [CrossRef]
- Konsoula, Z.; Liakopoulou-Kyriakides, M. Thermostable α-amylase production by Bacillus subtilis entrapped in calcium algi-nate gel capsules. Enzym. Microb. Technol. 2006, 39, 690–696. [Google Scholar] [CrossRef]
- Gond, S.K.; Bergen, M.S.; Torres, M.S.; White, J.F., Jr. Endophytic Bacillus spp. produce antifungal lipopeptides and induce host defence gene expression in maize. Microbiol. Res. 2015, 172, 79–87. [Google Scholar] [CrossRef]
- Cazorla, F.; Romero, D.; Pérez-García, A.; Lugtenberg, B.; Vicente, A.d.; Bloemberg, G. Isolation and characterization of an-tagonistic Bacillus subtilis strains from the avocado rhizoplane displaying biocontrol activity. J. Appl. Microbiol. 2007, 103, 1950–1959. [Google Scholar] [CrossRef] [PubMed]
- Elad, Y.; Stewart, A. Microbial control of Botrytis spp. In Botrytis: Biology, Pathology and Control; Elad, Y., Williamson, B., Tudzynski, P., Delen, N., Eds.; Springer: Dordrecht, The Netherlands, 2007; pp. 223–241. [Google Scholar]
- Ramírez-Cariño, H.F.; Guadarrama-Mendoza, P.C.; Sánchez-López, V.; Cuervo-Parra, J.A.; Ramírez-Reyes, T.; Dunlap, C.A.; Valadez-Blanco, R. Biocontrol of Alternaria alternata and Fusarium oxysporum by Trichoderma asperelloides and Bacillus paralicheniformis in tomato plants. Antonie van Leeuwenhoek 2020, 113, 1247–1261. [Google Scholar] [CrossRef]
- Hajare, S.N.; Gautam, S.; Sharma, A. A novel strain of Bacillus amyloliquefaciens displaying broad spectrum antifungal activity and its underlying mechanism. Ann. Microbiol. 2015, 66, 407–416. [Google Scholar] [CrossRef]
- Chung, S.; Kim, S.-D. Biological control of phytopathogenic fungi by Bacillus amyloliquefaciens 7079; suppression rates are better than popular chemical fungicides. J. Microbiol. Biotechnol. 2005, 15, 1011–1021. [Google Scholar]
- Qaiser, J.; Seong, L.Y.; Deok, J.H.; Kil Young, K. Effect of plant growth-promoting bacteria Bacillus amylliquefaciens Y1 on soil properties, pepper seedling growth, rhizosphere bacterial flora and soil enzymes. Plant Prot. Sci. 2018, 54, 129–137. [Google Scholar] [CrossRef]
- Kazerooni, E.A.; Maharachchikumbura, S.S.N.; Adhikari, A.; Al-Sadi, A.M.; Kang, S.-M.; Kim, L.-R.; Lee, I.-J. Rhizospheric Bacillus amyloliquefaciens Protects Capsicum annuum cv. Geumsugangsan from Multiple Abiotic Stresses via Multifarious Plant Growth-Promoting Attributes. Front. Plant Sci. 2021, 12. [Google Scholar] [CrossRef]
- Romero, A.; Carrion, G.; Rico-Gray, V. Fungal latent pathogens and endophytes from leaves of Parthenium hysterophorus (Asteraceae). Fungal Divers. 2001, 7, 81–87. [Google Scholar]
- Al-Sadi, A.M.; Al-Masoodi, R.S.; Al-Ismaili, M.; Al-Mahmooli, I.H. Population Structure and Development of Resistance to Hymexazol Among Fusarium solani Populations from Date Palm, Citrus and Cucumber. J. Phytopathol. 2015, 163, 947–955. [Google Scholar] [CrossRef]
- Berbee, M.; Pirseyedi, M.; Hubbard, S. Cochliobolus phylogenetics and the origin of known, highly virulent pathogens, inferred from ITS and glyceraldehyde-3-phosphate dehydrogenase gene sequences. Mycologia 1999, 91, 964–977. [Google Scholar] [CrossRef]
- Hong, S.G.; Cramer, R.A.; Lawrence, C.B.; Pryor, B.M. Alt a 1 allergen homologs from Alternaria and related taxa: Analysis of phylogenetic content and secondary structure. Fungal Genet. Biol. 2005, 42, 119–129. [Google Scholar] [CrossRef]
- Al Ghafri, A.; Maharachchikumbura, S.S.N.; Hyde, K.D.; Al-Saady, N.A.; Al-Sadi, A.M. A new section and a new species of Alternaria encountered from Oman. Phytotaxa 2019, 405, 279–289. [Google Scholar] [CrossRef]
- Silvestro, D.; Michalak, I. raxmlGUI: A graphical front-end for RAxML. Org. Divers. Evol. 2012, 12, 335–337. [Google Scholar] [CrossRef]
- Ji, S.H.; Gururani, M.; Chun, S.-C. Isolation and characterization of plant growth promoting endophytic diazotrophic bacteria from Korean rice cultivars. Microbiol. Res. 2014, 169, 83–98. [Google Scholar] [CrossRef]
- Heckman, C.; Kanagasundaram, S.; Cayer, M.; Paige, J. Preparation of cultured cells for scanning electron microscope. Protoc. Exch. 2007. [Google Scholar] [CrossRef]
- Cappuccino, J.; Sherman, N. Biochemical Activities of Microorganisms. Microbiology, A Laboratory Manual; The Benjamin/Cummings Publishing Co.: Menlo Park, CA, USA, 1992; pp. 188–247. [Google Scholar]
- Schaad, N.; Jones, J.; Chun, W. Laboratory Guide for Identification of Plant Pathogenic Bacteria; Schad, N.W., Ed.; The American Phytopathological Society: Saint Paul, MN, USA, 1992. [Google Scholar]
- Mittal, A.; Singh, G.; Goyal, V.; Yadav, A.; Aneja, K.R.; Gautam, S.K.; Aggarwal, N.K. Isolation and Biochemical Characteri-Zation of Acido-Thermophilic Extracellular Phytase Producing Bacterial Strain for Potential Application in Poultry Feed. Jundishapur J. Microbiol. 2011, 4, 273–282. [Google Scholar]
- Gopinath, S.C.B.; Hilda, A.; Anbu, P. Extracellular enzymatic activity profiles in fungi isolated from oil-rich environments. Mycoscience 2005, 46, 119–126. [Google Scholar] [CrossRef]
- Harrigan, W.F. Laboratory Methods in Food Microbiology; Gulf Professional Publishing: Oxford, UK, 1998. [Google Scholar]
- Conceição, D.; de Angelis, D.; Bidoia, E.; de Angelis, D. Fungos filamentosos isolados do rio Atibaia, SP e refinaria de petróleo biodegradadores de compostos fenólicos. Rev. Inst. Biológico 2005, 72, 99–106. [Google Scholar]
- Balasubramanian, V.; Vashisht, D.; Cletus, J.; Sakthivel, N. Plant β-1, 3-glucanases: Their biological functions and transgenic expression against phytopathogenic fungi. Biotechnol. Lett. 2012, 34, 1983–1990. [Google Scholar] [CrossRef] [PubMed]
- Benito, E.P.; Have, A.T.; Klooster, J.W.V.; van Kan, J.A. Fungal and plant gene expression during synchronized infection of tomato leaves by Botrytis cinerea. Eur. J. Plant Pathol. 1998, 104, 207–220. [Google Scholar] [CrossRef]
- AlBdaiwi, R.N.; Khyami-Horani, H.; Ayad, J.; Alananbeh, K.M.; Al-Sayaydeh, R. Isolation and Characterization of Halotolerant Plant Growth Promoting Rhizobacteria from Durum Wheat (Triticum turgidum subsp. durum) Cultivated in Saline Areas of the Dead Sea Region. Front. Microbiol. 2019, 10, 1639. [Google Scholar] [CrossRef]
- Ke, Q.; Ye, J.; Wang, B.; Ren, J.; Yin, L.; Deng, X.; Wang, S. Melatonin Mitigates Salt Stress in Wheat Seedlings by Modulating Polyamine Metabolism. Front. Plant Sci. 2018, 9, 914. [Google Scholar] [CrossRef] [PubMed]
- Dutta, S.; Woo, E.-E.; Yu, S.-M.; Nagendran, R.; Yun, B.-S.; Lee, Y.H. Control of Anthracnose and Gray Mold in Pepper Plants Using Culture Extract of White-Rot Fungus and Active Compound Schizostatin. Mycobiology 2019, 47, 87–96. [Google Scholar] [CrossRef]
- Al-Nadabi, H.; Maharachchikumbura, S.S.; Al-Gahaffi, Z.S.; Al-Hasani, A.S.; Velazhahan, R.; Al-Sadi, A.M. Molecular iden-tification of fungal pathogens associated with leaf spot disease of date palms (Phoenix dactylifera). All Life 2020, 13, 587–597. [Google Scholar] [CrossRef]
- Arnon, D.I. Copper Enzymes in Isolated Chloroplasts. Polyphenoloxidase in Beta Vulgaris. Plant Physiol. 1949, 24, 1–15. [Google Scholar] [CrossRef] [PubMed]
- Wu, Y.; Hu, B. Simultaneous determination of several phytohormones in natural coconut juice by hollow fiber-based liquid–liquid–liquid microextraction-high performance liquid chromatography. J. Chromatogr. A 2009, 1216, 7657–7663. [Google Scholar] [CrossRef] [PubMed]
- Enyedi, A.J.; Yalpani, N.; Silverman, P.; Raskin, I. Localization, conjugation, and function of salicylic acid in tobacco during the hypersensitive reaction to tobacco mosaic virus. Proc. Natl. Acad. Sci. USA 1992, 89, 2480–2484. [Google Scholar] [CrossRef]
- Seskar, M.; Shulaev, V.; Raskin, I. Endogenous Methyl Salicylate in Pathogen-Inoculated Tobacco Plants. Plant Physiol. 1998, 116, 387–392. [Google Scholar] [CrossRef]
- Waqas, M.; Khan, A.L.; Hamayun, M.; Shahzad, R.; Kim, Y.-H.; Choi, K.S.; Lee, I.-J. Endophytic infection alleviates biotic stress in sunflower through regulation of defence hormones, antioxidants and functional amino acids. Eur. J. Plant Pathol. 2015, 141, 803–824. [Google Scholar] [CrossRef]
- Ashraf, M.; Iram, A. Drought stress induced changes in some organic substances in nodules and other plant parts of two po-tential legumes differing in salt tolerance. Flora-Morphol. Distrib. Funct. Ecol. Plants 2005, 200, 535–546. [Google Scholar] [CrossRef]
- Khan, A.L.; Al-Harrasi, A.; Shahzad, R.; Imran, Q.M.; Yun, B.-W.; Kim, Y.-H.; Kang, S.-M.; Al-Rawahi, A.; Lee, I.-J. Regulation of endogenous phytohormones and essential metabolites in frankincense-producing Boswellia sacra under wounding stress. Acta Physiol. Plant. 2018, 40, 113. [Google Scholar] [CrossRef]
- Putter, J. Peroxidase. In Methods of Enzymatic Analysis; Bergmeyer, H., Ed.; Chemie: Weinhan, Germany, 1974; pp. 685–690. [Google Scholar]
- Esirhindi, G.; Mir, M.A.; Abd-Allah, E.F.; Eahmad, P.; Egucel, S. Jasmonic Acid Modulates the Physio-Biochemical Attributes, Antioxidant Enzyme Activity, and Gene Expression in Glycine max under Nickel Toxicity. Front. Plant Sci. 2016, 7, 591. [Google Scholar] [CrossRef]
- Wang, L.; Chen, W.J.; Wang, Q.; Eneji, A.E.; Li, Z.H.; Duan, L.S. Coronatine Enhances Chilling Tolerance in Cucumber (Cucumis sativus L.) Seedlings by Improving the Antioxidative Defence System. J. Agron. Crop. Sci. 2009, 195, 377–383. [Google Scholar] [CrossRef]
- Barka, E.A.; Nowak, J.; Clément, C. Enhancement of Chilling Resistance of Inoculated Grapevine Plantlets with a Plant Growth-Promoting Rhizobacterium, Burkholderia phytofirmans Strain PsJN. Appl. Environ. Microbiol. 2006, 72, 7246–7252. [Google Scholar] [CrossRef]
- Li, M.-W.; Muñoz, N.; Wong, C.-F.; Wong, F.-L.; Wong, K.-S.; Wong, J.W.-H.; Qi, X.; Li, K.-P.; Ng, M.-S.; Lam, H.-M. QTLs Regulating the Contents of Antioxidants, Phenolics, and Flavonoids in Soybean Seeds Share a Common Genomic Region. Front. Plant Sci. 2016, 7, 854. [Google Scholar] [CrossRef]
- Zheng, W.; Wang, S.Y. Antioxidant Activity and Phenolic Compounds in Selected Herbs. J. Agric. Food Chem. 2001, 49, 5165–5170. [Google Scholar] [CrossRef] [PubMed]
- Jana, S.; Choudhuri, M.A. Glycolate metabolism of three submersed aquatic angiosperms during ageing. Aquat. Bot. 1982, 12, 345–354. [Google Scholar] [CrossRef]
- Tsai, Y.-C.; Hong, C.-Y.; Liu, L.-F.; Kao, C.H. Expression of ascorbate peroxidase and glutathione reductase in roots of rice seedlings in response to NaCl and H2O2. J. Plant Physiol. 2005, 162, 291–299. [Google Scholar] [CrossRef]
- López-Serrano, L.; Canet-Sanchis, G.; Selak, G.V.; Penella, C.; Bautista, A.S.; López-Galarza, S.; Calatayud, Á. Pepper Rootstock and Scion Physiological Responses Under Drought Stress. Front. Plant Sci. 2019, 10, 38. [Google Scholar] [CrossRef]
- Imran, Q.M.; Hussain, A.; Mun, B.-G.; Lee, S.U.; Asaf, S.; Ali, M.A.; Lee, I.-J.; Yun, B.-W. Transcriptome wide identification and characterization of NO-responsive WRKY transcription factors in Arabidopsis thaliana L. Environ. Exp. Bot. 2018, 148, 128–143. [Google Scholar] [CrossRef]
- Annapurna, K.; Kumar, A.; Kumar, L.V.; Govindasamy, V.; Bose, P.; Ramadoss, D. PGPR-Induced Systemic Resistance (ISR) in plant disease management. In Bacteria in Agrobiology: Disease Management; Springer: Berlin/Heidelberg, Germany, 2013; pp. 405–425. [Google Scholar]
- Harish, S.; Parthasarathy, S.; Durgadevi, D.; Anandhi, K.; Raguchander, T. Plant Growth-Promoting Rhizobacteria: Har-nessing Its Potential for Sustainable Plant Disease Management. In Plant Growth Promoting Rhizobacteria for Agricultural Sustainability: From Theory to Practices; Kumar, A., Meena, V.S., Eds.; Springer: Singapore, 2019; pp. 151–187. [Google Scholar]
- Buerkert, A.; Marschner, H. Calcium and temperature effects on seedling exudation and root rot infection of common bean on an acid sandy soil. Plant Soil 1992, 147, 293–303. [Google Scholar] [CrossRef]
- Sugimoto, T.; Watanabe, K.; Yoshida, S.; Aino, M.; Furiki, M.; Shiono, M.; Matoh, T.; Biggs, A.R. Field Application of Calcium to Reduce Phytophthora Stem Rot of Soybean, and Calcium Distribution in Plants. Plant Dis. 2010, 94, 812–819. [Google Scholar] [CrossRef]
- Bhattacharyya, P.N.; Jha, D.K. Plant growth-promoting rhizobacteria (PGPR): Emergence in agriculture. World J. Microbiol. Biotechnol. 2012, 28, 1327–1350. [Google Scholar] [CrossRef] [PubMed]
- Izanloo, A.; Condon, A.G.; Langridge, P.; Tester, M.; Schnurbusch, T. Different mechanisms of adaptation to cyclic water stress in two South Australian bread wheat cultivars. J. Exp. Bot. 2008, 59, 3327–3346. [Google Scholar] [CrossRef] [PubMed]
- Pii, Y.; Mimmo, T.; Tomasi, N.; Terzano, R.; Cesco, S.; Crecchio, C. Microbial interactions in the rhizosphere: Beneficial influ-ences of plant growth-promoting rhizobacteria on nutrient acquisition process. A review. Biol. Fertil. Soils 2015, 51, 403–415. [Google Scholar] [CrossRef]
- Adesemoye, A.; Torbert, H.; Kloepper, J. Enhanced plant nutrient use efficiency with PGPR and AMF in an integrated nutrient management system. Can. J. Microbiol. 2008, 54, 876–886. [Google Scholar] [CrossRef] [PubMed]
- Khan, N.; Ali, S.; Tariq, H.; Latif, S.; Yasmin, H.; Mehmood, A.; Shahid, M. Water Conservation and Plant Survival Strategies of Rhizobacteria under Drought Stress. Agronomy 2020, 10, 1683. [Google Scholar] [CrossRef]
- Singh, A.; Chauhan, P.S. Ecological Significance of Soil-Associated Plant Growth-Promoting Biofilm-Forming Microbes for Stress Management. In Biofilms in Plant and Soil Health; Wiley: Hoboken, NJ, USA, 2017; pp. 291–326. [Google Scholar]
- Harada, T.; Torii, Y.; Morita, S.; Onodera, R.; Hara, Y.; Yokoyama, R.; Nishitani, K.; Satoh, S. Cloning, characterization, and expression of xyloglucan endotransglucosylase/hydrolase and expansin genes associated with petal growth and development during carnation flower opening. J. Exp. Bot. 2010, 62, 815–823. [Google Scholar] [CrossRef] [PubMed]
- Cho, S.K.; Kim, J.E.; Park, J.-A.; Eom, T.J.; Kim, W.T. Constitutive expression of abiotic stress-inducible hot pepper CaXTH3, which encodes a xyloglucan endotransglucosylase/hydrolase homolog, improves drought and salt tolerance in transgenic Arabidopsis plants. FEBS Lett. 2006, 580, 3136–3144. [Google Scholar] [CrossRef]
- Choi, J.Y.; Seo, Y.S.; Kim, S.J.; Kim, W.T.; Shin, J.S. Constitutive expression of CaXTH3, a hot pepper xyloglucan endo-transglucosylase/hydrolase, enhanced tolerance to salt and drought stresses without phenotypic defects in tomato plants (So-lanum lycopersicum cv. Dotaerang). Plant Cell 2011, 30, 867–877. [Google Scholar] [CrossRef] [PubMed]
- Xu, W.; Purugganan, M.M.; Polisensky, D.H.; Antosiewicz, D.M.; Fry, S.C.; Braam, J. Arabidopsis TCH4, regulated by hormones and the environment, encodes a xyloglucan endotransglycosylase. Plant Cell 1995, 7, 1555–1567. [Google Scholar] [CrossRef] [PubMed]
- Muñoz-Bertomeu, J.; Lorences, E.P. Changes in xyloglucan endotransglucosylase/hydrolase (XTHs) expression and XET activity during apple fruit infection by Penicillium expansum Link. A. Eur. J. Plant Pathol. 2014, 138, 273–282. [Google Scholar] [CrossRef]
- Han, Y.; Wang, W.; Sun, J.; Ding, M.; Zhao, R.; Deng, S.; Wang, F.; Hu, Y.; Wang, Y.; Lu, Y. Populus euphratica XTH over-expression enhances salinity tolerance by the development of leaf succulence in transgenic tobacco plants. J. Exp. Bot. 2013, 64, 4225–4238. [Google Scholar] [CrossRef]
- Edenancé, N.; Esánchez-Vallet, A.; Egoffner, D.; Emolina, A. Disease resistance or growth: The role of plant hormones in balancing immune responses and fitness costs. Front. Plant Sci. 2013, 4, 155. [Google Scholar] [CrossRef]
- Wani, A.B.; Chadar, H.; Singh, S.; Upadhyay, N. Salicylic acid to decrease plant stress. Environ. Chem. Lett. 2017, 15, 101–123. [Google Scholar] [CrossRef]
- Nazar, R.; Iqbal, N.; Syeed, S.; Khan, N.A. Salicylic acid alleviates decreases in photosynthesis under salt stress by enhancing nitrogen and sulfur assimilation and antioxidant metabolism differentially in two mungbean cultivars. J. Plant Physiol. 2011, 168, 807–815. [Google Scholar] [CrossRef] [PubMed]
- Melotto, M.; Underwood, W.; Koczan, J.; Nomura, K.; He, S.Y. Plant stomata function in innate immunity against bacterial invasion. Cell 2006, 126, 969–980. [Google Scholar] [CrossRef]
- Sánchez-Vallet, A.; López, G.; Ramos, B.; Delgado-Cerezo, M.; Riviere, M.-P.; Llorente, F.; Fernández, P.V.; Miedes, E.; Estevez, J.M.; Grant, M.; et al. Disruption of Abscisic Acid Signaling Constitutively Activates Arabidopsis Resistance to the Necrotrophic Fungus Plectosphaerella cucumerina. Plant Physiol. 2012, 160, 2109–2124. [Google Scholar] [CrossRef]
- Zabala, M.D.T.; Bennett, M.H.; Truman, W.H.; Grant, M.R. Antagonism between salicylic and abscisic acid reflects early host-pathogen conflict and moulds plant defence responses. Plant J. 2009, 59, 375–386. [Google Scholar] [CrossRef]
- Yu, F.; Wu, Y.; Xie, Q. Ubiquitin–Proteasome System in ABA Signaling: From Perception to Action. Mol. Plant 2016, 9, 21–33. [Google Scholar] [CrossRef]
- Joo, H.; Lim, C.W.; Lee, S.C. A pepper RING-type E3 ligase, CaASRF1, plays a positive role in drought tolerance via modulation of CaAIBZ1 stability. Plant J. 2018, 98, 5–18. [Google Scholar] [CrossRef] [PubMed]
- Shikata, M.; Koyama, T.; Mitsuda, N.; Ohme-Takagi, M. Arabidopsis SBP-box genes SPL10, SPL11 and SPL2 control morphological change in association with shoot maturation in the reproductive phase. Plant Cell Physiol. 2009, 50, 2133–2145. [Google Scholar] [CrossRef] [PubMed]
- Zhang, H.-X.; Jin, J.-H.; He, Y.-M.; Lu, B.-Y.; Li, D.-W.; Chai, W.-G.; Khan, A.; Gong, Z.-H. Genome-Wide Identification and Analysis of the SBP-Box Family Genes under Phytophthora capsici Stress in Pepper (Capsicum annuum L.). Front. Plant Sci. 2016, 7, 504. [Google Scholar] [CrossRef]
- Hou, H.; Yan, Q.; Wang, X.; Xu, H. A SBP-Box Gene VpSBP5 from Chinese Wild Vitis Species Responds to Erysiphe necator and Defense Signaling Molecules. Plant Mol. Biol. Rep. 2013, 31, 1261–1270. [Google Scholar] [CrossRef]
- Zhang, H.-X.; Feng, X.-H.; Jin, J.-H.; Khan, A.; Guo, W.-L.; Du, X.-H.; Gong, Z.-H. CaSBP11 Participates in the Defense Re-sponse of Pepper to Phytophthora capsici through Regulating the Expression of Defense-Related Genes. Int. J. Mol. Sci. 2020, 21, 9065. [Google Scholar] [CrossRef] [PubMed]
- Rizhsky, L.; Davletova, S.; Liang, H.; Mittler, R. The Zinc Finger Protein Zat12 Is Required for Cytosolic Ascorbate Peroxidase 1 Expression during Oxidative Stress in Arabidopsis. J. Biol. Chem. 2004, 279, 11736–11743. [Google Scholar] [CrossRef] [PubMed]
- Oh, S.-K.; Yi, S.Y.; Yu, S.H.; Moon, J.S.; Park, J.M.; Choi, D. CaWRKY2, a chili pepper transcription factor, is rapidly induced by incompatible plant pathogens. Mol. Cells 2006, 22, 58–64. [Google Scholar]
- Cheng, Y.; JalalAhammed, G.; Yu, J.; Yao, Z.; Ruan, M.; Ye, Q.; Li, Z.; Wang, R.; Feng, K.; Zhou, G.; et al. Putative WRKYs associated with regulation of fruit ripening revealed by detailed expression analysis of the WRKY gene family in pepper. Sci. Rep. 2016, 6, 39000. [Google Scholar] [CrossRef]
- Pandey, S.P.; Somssich, I.E. The Role of WRKY Transcription Factors in Plant Immunity. Plant Physiol. 2009, 150, 1648–1655. [Google Scholar] [CrossRef]
- Xie, Z.; Zhang, Z.-L.; Zou, X.; Huang, J.; Ruas, P.; Thompson, D.B.; Shen, Q.J. Annotations and Functional Analyses of the Rice WRKY Gene Superfamily Reveal Positive and Negative Regulators of Abscisic Acid Signaling in Aleurone Cells. Plant Physiol. 2005, 137, 176–189. [Google Scholar] [CrossRef]
- Dong, J.; Chen, C.; Chen, Z. Expression profiles of the Arabidopsis WRKY gene superfamily during plant defense response. Plant Mol. Biol. 2003, 51, 21–37. [Google Scholar] [CrossRef]
- Wang, H.; Niu, H.; Zhai, Y.; Lu, M. Characterization of BiP Genes from Pepper (Capsicum annuum L.) and the Role of CaBiP1 in Response to Endoplasmic Reticulum and Multiple Abiotic Stresses. Front. Plant Sci. 2017, 8, 1122. [Google Scholar] [CrossRef]
- Sung, D.Y.; Vierling, E.; Guy, C.L. Comprehensive Expression Profile Analysis of the Arabidopsis Hsp70 Gene Family. Plant Physiol. 2001, 126, 789–800. [Google Scholar] [CrossRef]
- Howell, S.H. Endoplasmic Reticulum Stress Responses in Plants. Annu. Rev. Plant Biol. 2013, 64, 477–499. [Google Scholar] [CrossRef]
- Mori, K. Tripartite Management of Unfolded Proteins in the Endoplasmic Reticulum. Cell 2000, 101, 451–454. [Google Scholar] [CrossRef]
- Williams, B.; Verchot, J.; Dickman, M.B. When supply does not meet demand-ER stress and plant programmed cell death. Front. Plant Sci. 2014, 5, 211. [Google Scholar] [CrossRef]
- Künstler, A.; Bacsó, R.; Hafez, Y.M.; Király, L. Reactive oxygen species and plant disease resistance. In Reactive Oxygen Species and Oxidative Damage in Plants Under Stress; Gupta, D.K., Palma, J.M., Corpas, F.J., Eds.; Springer: Cham, Switzerland, 2015; pp. 269–303. [Google Scholar]
- Batool, T.; Ali, S.; Seleiman, M.F.; Naveed, N.H.; Ali, A.; Ahmed, K.; Abid, M.; Rizwan, M.; Shahid, M.R.; Alotaibi, M.; et al. Plant growth promoting rhizobacteria alleviates drought stress in potato in response to suppressive oxidative stress and antioxidant enzymes activities. Sci. Rep. 2020, 10, 1–19. [Google Scholar] [CrossRef]
- Singh, R.P.; Jha, P.; Jha, P.N. The plant-growth-promoting bacterium Klebsiella sp. SBP-8 confers induced systemic tolerance in wheat (Triticum aestivum) under salt stress. J. Plant Physiol. 2015, 184, 57–67. [Google Scholar] [CrossRef] [PubMed]
- Han, H.; Lee, K. Physiological responses of soybean-inoculation of Bradyrhizobium japonicum with PGPR in saline soil con-ditions. Res. J. Agric. Biol. Sci. 2005, 1, 216–221. [Google Scholar]
- Hückelhoven, R. BAX Inhibitor-1, an ancient cell death suppressor in animals and plants with prokaryotic relatives. Apoptosis 2004, 9, 299–307. [Google Scholar] [CrossRef] [PubMed]
- Jaiswal, V.; Gahlaut, V.; Dubey, M.; Ramchiary, N. Genes/Quantitative Trait Loci and Associated Molecular Mechanisms Identified in Capsicum Genome for Tolerance to Abiotic and Biotic Stresses. In Compendium of Plant Genomes; Springer: Cham, 2019; pp. 121–138. [Google Scholar]
- Isbat, M.; Zeba, N.; Kim, S.R.; Hong, C.B. A BAX inhibitor-1 gene in Capsicum annuum is induced under various abiotic stresses and endows multi-tolerance in transgenic tobacco. J. Plant Physiol. 2009, 166, 1685–1693. [Google Scholar] [CrossRef]
- Lu, P.-P.; Yu, T.-F.; Zheng, W.-J.; Chen, M.; Zhou, Y.-B.; Chen, J.; Ma, Y.-Z.; Xi, Y.-J.; Xu, Z.-S. The Wheat Bax Inhibitor-1 Protein Interacts with an Aquaporin TaPIP1 and Enhances Disease Resistance in Arabidopsis. Front. Plant Sci. 2018, 9, 20. [Google Scholar] [CrossRef]
- Dumanović, J.; Nepovimova, E.; Natić, M.; Kuča, K.; Jaćević, V. The Significance of Reactive Oxygen Species and Antioxidant Defense System in Plants: A Concise Overview. Front. Plant Sci. 2021, 11. [Google Scholar] [CrossRef]
- Fenando, E.; Boero, C.; Gallardo, M.; Gonzalez, J. Effect of NaCl on germination, growth, and soluble suger content in Che-nopodium quinona seeds. Bot. Bull. Acad. Sin. 2000, 41, 27–34. [Google Scholar]
- Morkunas, I.; Ratajczak, L. The role of sugar signaling in plant defense responses against fungal pathogens. Acta Physiol. Plant. 2014, 36, 1607–1619. [Google Scholar] [CrossRef]
- Wang, L.; Ruan, Y.-L. Regulation of cell division and expansion by sugar and auxin signaling. Front. Plant Sci. 2013, 4, 163. [Google Scholar] [CrossRef]
- Van Oosten, J.J.; Besford, R. Some relationships between the gas exchange, biochemistry and molecular biology of photosyn-thesis during leaf development of tomato plants after transfer to different carbon dioxide concentrations. Plant Cell Environ. 1995, 18, 1253–1266. [Google Scholar] [CrossRef]
- Zeier, J. New insights into the regulation of plant immunity by amino acid metabolic pathways. Plant Cell Environ. 2013, 36, 2085–2103. [Google Scholar] [CrossRef] [PubMed]
- Qamar, A.; Mysore, K.S.; Senthil-Kumar, M. Role of proline and pyrroline-5-carboxylate metabolism in plant defense against invading pathogens. Front. Plant Sci. 2015, 6, 503. [Google Scholar] [CrossRef] [PubMed]
- Cecchini, N.M.; Monteoliva, M.I.; Alvarez, M.E. Proline Dehydrogenase Contributes to Pathogen Defense in Arabidopsis. Plant Physiol. 2011, 155, 1947–1959. [Google Scholar] [CrossRef] [PubMed]
- Fabro, G.; Kovács, I.; Pavet, V.; Szabados, L.; Alvarez, M.E. Proline Accumulation and AtP5CS2 Gene Activation Are Induced by Plant-Pathogen Incompatible Interactions in Arabidopsis. Mol. Plant-Microbe Interact. 2004, 17, 343–350. [Google Scholar] [CrossRef]
- Kim, J.; Liu, Y.; Zhang, X.; Zhao, B.; Childs, K.L. Analysis of salt-induced physiological and proline changes in 46 switchgrass (Panicum virgatum) lines indicates multiple response modes. Plant Physiol. Biochem. 2016, 105, 203–212. [Google Scholar] [CrossRef] [PubMed]
- Kunkel, B.N.; Brooks, D.M. Cross talk between signaling pathways in pathogen defense. Curr. Opin. Plant Biol. 2002, 5, 325–331. [Google Scholar] [CrossRef]
- Hammond-Kosack, K.E.; Parker, J.E. Deciphering plant–pathogen communication: Fresh perspectives for molecular resistance breeding. Curr. Opin. Biotechnol. 2003, 14, 177–193. [Google Scholar] [CrossRef]
- Dodds, P.N.; Rathjen, J. Plant immunity: Towards an integrated view of plant–pathogen interactions. Nat. Rev. Genet. 2010, 11, 539–548. [Google Scholar] [CrossRef]
- Lee, S.C.; Hwang, I.S.; Choi, H.W.; Hwang, B.K. Involvement of the Pepper Antimicrobial Protein CaAMP1 Gene in Broad Spectrum Disease Resistance. Plant Physiol. 2008, 148, 1004–1020. [Google Scholar] [CrossRef]
- Gao, A.-G.; Hakimi, S.M.; Mittanck, C.A.; Wu, Y.; Woerner, B.M.; Stark, D.M.; Shah, D.M.; Liang, J.; Rommens, C.M. Fungal pathogen protection in potato by expression of a plant defensin peptide. Nat. Biotechnol. 2000, 18, 1307–1310. [Google Scholar] [CrossRef] [PubMed]
- DeGray, G.; Rajasekaran, K.; Smith, F.; Sanford, J.; Daniell, H. Expression of an antimicrobial peptide via the chloroplast ge-nome to control phytopathogenic bacteria and fungi. Plant Physiol. 2001, 127, 852–862. [Google Scholar] [CrossRef] [PubMed]
- Niu, L.; Zhong, X.; Zhang, Y.; Yang, J.; Xing, G.; Li, H.; Liu, D.; Ma, R.; Dong, Y.; Yang, X. Enhanced tolerance to Phytophthora root and stem rot by over-expression of the plant antimicrobial peptide CaAMP1 gene in soybean. BMC Genet. 2020, 21, 1–10. [Google Scholar] [CrossRef]
- Tantong, S.; Pringsulaka, O.; Weerawanich, K.; Meeprasert, A.; Rungrotmongkol, T.; Sarnthima, R.; Roytrakul, S.; Sirikantaramas, S. Two novel antimicrobial defensins from rice identified by gene coexpression network analyses. Peptides 2016, 84, 7–16. [Google Scholar] [CrossRef]
- Wang, J.-E.; Li, D.-W.; Zhang, Y.-L.; Zhao, Q.; He, Y.-M.; Gong, Z.-H. Defence responses of pepper (Capsicum annuum L.) infected with incompatible and compatible strains of Phytophthora capsici. Eur. J. Plant Pathol. 2013, 136, 625–638. [Google Scholar] [CrossRef]
- La Spada, F.; Stracquadanio, C.; Riolo, M.; Pane, A.; Cacciola, S.O. Trichoderma Counteracts the Challenge of Phytophthora nicotianae Infections on Tomato by Modulating Plant Defense Mechanisms and the Expression of Crinkler, Necrosis-Inducing Phytophthora Protein 1, and Cellulose-Binding Elicitor Lectin Pathogenic Effectors. Front. Plant Sci. 2020, 11. [Google Scholar] [CrossRef]

| Symbol | Treatment |
|---|---|
| Cont | treated with sterile distilled water |
| PGPR | treated with PGPR |
| BOT | treated with BOT |
| BOT+PGPR | treated with BOT + PGPR |
| ALT | treated with ALT |
| ALT + PGPR | treated with ALT + PGPR |
| Bacterial Isolate | Isolated Host | Accession No. | Hydrolytic Enzyme Production | Inhibition (mm) | |||||||||
|---|---|---|---|---|---|---|---|---|---|---|---|---|---|
| Amylase | Protease | Pectinase | Cellulase | Lipase | Catalase | Glucanase | Laccase | Phytase | ALT | BOT | |||
| Bacillus amyloliquefaciens | Sasamorpha borealis | MW599955 | + | + | + | + | + | + | + | + | + | 65.66 ± 1.0 | 69.50 ± 0.5 |
| Treatment | Plant Height | Stem Diameter | Leaf Length | Leaf Width | Total Plant Fresh Weight | Chla | Chlb | Total Chl | Carotenoid | No. Leaf |
|---|---|---|---|---|---|---|---|---|---|---|
| (cm) | (cm) | (cm) | (cm) | (g) | µg/g FW | µg/g FW | (µg/g FW) | µg/g FW | ||
| 8DAT | ||||||||||
| Cont | 20.3 ± 0.3 c | 0.3 ± 0.02 a | 9.1 ±0.03 c | 5.3 ± 0.2 d | 12.0 ± 0.05 c | 21.8 ± 7.2 e | 25.9 ± 2.5 b | 107.63 ± 1.7 d | 1.0 ± 0.2 d | 16.0 ± 0.0 b |
| PGPR | 20.5 ± 0.1 b | 0.3 ± 0.05 a | 10.7 ± 0.3 a | 6.6 ± 0.1 a | 16.2 ± 0.06 a | 24.2 ± 6.0 c | 28.0 ± 7.1 a | 118.7 ± 1.6 c | 1.2 ± 0.5 c | 17.6 ± 0.3 a |
| BOT | 14.6 ± 0.3 f | 0.2 ± 0.002 b | 7.6 ± 0.5 d | 4.0 ± 0.2 e | 7.95 ± 0.15 f | 22.1 ± 2.9 d | 12.5 ± 0.7 d | 96.9 ± 1.3 e | 0.8 ± 3.1 e | 13.3 ± 0.0 e |
| BOT + PGPR | 21.6 ± 0.1 a | 0.3 ± 0.01 a | 9.5 ± 0.3 b | 5.7 ± 0.1 b | 12.20 ± 0.20 b | 34.9 ± 7.6 b | 13.2 ± 1.0 c | 140.58 ± 1.7 b | 1.9 ± 2.3 a | 16.0 ± 0.0 b |
| ALT | 15.8 ± 0.4 e | 0.2 ± 0.01 b | 6.6 ± 0.1 e | 3.8 ± 0.1 f | 8.30 ± 0.30 e | 15.9 ± 1.4 f | 6.0 ± 2.0 f | 64.21 ± 4.4 f | 0.6 ± 3.5 f | 15.0 ± 0.5 d |
| ALT + PGPR | 19.3 ± 0.3 d | 0.3 ± 0.008 a | 9.1 ± 0.2 c | 5.5 ± 0.1 c | 11.25 ± 0.25 d | 39.2 ± 7.9 a | 10.1 ± 1.3 e | 152.46 ± 8.4 a | 1.8 ± 3.8 b | 15.6 ± 0.3 c |
| Sample Name | Ca (ug/kg) | K (ug/kg) | P (ug/kg) |
|---|---|---|---|
| 8DAT-Plant | |||
| Cont | 6.45 ± 0.05 d | 43.31 ± 1.31 d | 5.01 ± 0.01 d |
| PGPR | 8.38 ± 0.18 a | 49.64 ± 0.5 c | 6.76 ± 0.23 b |
| BOT | 6.15 ± 0.15 e | 43.01 ± 1.0 e | 4.66 ± 0.26 e |
| BOT+PGPR | 7.50 ± 0.20 b | 53.14 ± 0.86 a | 5.96 ± 0.04 c |
| ALT | 5.93 ± 0.13 f | 41.38 ± 0.58 f | 4.43 ± 0.23 f |
| ALT + PGPR | 6.94 ± 0.05 c | 52.70 ± 0.30 b | 6.95 ± 0.04 a |
Publisher’s Note: MDPI stays neutral with regard to jurisdictional claims in published maps and institutional affiliations. |
© 2021 by the authors. Licensee MDPI, Basel, Switzerland. This article is an open access article distributed under the terms and conditions of the Creative Commons Attribution (CC BY) license (https://creativecommons.org/licenses/by/4.0/).
Share and Cite
Kazerooni, E.A.; Maharachchikumbura, S.S.N.; Al-Sadi, A.M.; Kang, S.-M.; Yun, B.-W.; Lee, I.-J. Biocontrol Potential of Bacillus amyloliquefaciens against Botrytis pelargonii and Alternaria alternata on Capsicum annuum. J. Fungi 2021, 7, 472. https://doi.org/10.3390/jof7060472
Kazerooni EA, Maharachchikumbura SSN, Al-Sadi AM, Kang S-M, Yun B-W, Lee I-J. Biocontrol Potential of Bacillus amyloliquefaciens against Botrytis pelargonii and Alternaria alternata on Capsicum annuum. Journal of Fungi. 2021; 7(6):472. https://doi.org/10.3390/jof7060472
Chicago/Turabian StyleKazerooni, Elham Ahmed, Sajeewa S. N. Maharachchikumbura, Abdullah Mohammed Al-Sadi, Sang-Mo Kang, Byung-Wook Yun, and In-Jung Lee. 2021. "Biocontrol Potential of Bacillus amyloliquefaciens against Botrytis pelargonii and Alternaria alternata on Capsicum annuum" Journal of Fungi 7, no. 6: 472. https://doi.org/10.3390/jof7060472
APA StyleKazerooni, E. A., Maharachchikumbura, S. S. N., Al-Sadi, A. M., Kang, S.-M., Yun, B.-W., & Lee, I.-J. (2021). Biocontrol Potential of Bacillus amyloliquefaciens against Botrytis pelargonii and Alternaria alternata on Capsicum annuum. Journal of Fungi, 7(6), 472. https://doi.org/10.3390/jof7060472

